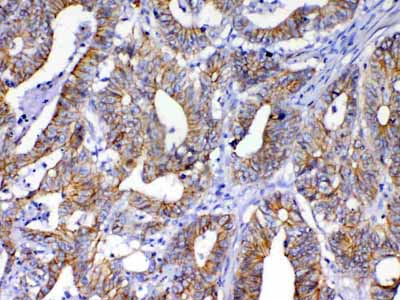

- SELECT id FROM application WHERE name = 'DB'
- DB [1] SELECT id FROM application WHERE name = 'EIA'
- EIA [1] SELECT id FROM application WHERE name = 'ELISA'
- ELISA [2,075] SELECT id FROM application WHERE name = 'ELISPOT'
- ELISPOT [4] SELECT id FROM application WHERE name = 'FA'
- FA [27] SELECT id FROM application WHERE name = 'FC'
- FC [8,225] SELECT id FROM application WHERE name = 'ICC'
- ICC [1,611] SELECT id FROM application WHERE name = 'ID'
- ID [4] SELECT id FROM application WHERE name = 'IEM'
- IEM [1] SELECT id FROM application WHERE name = 'IF'
- IF [3,139] SELECT id FROM application WHERE name = 'IHC'
- IHC [2,093] SELECT id FROM application WHERE name = 'IHC-Fr'
- IHC-Fr [185] SELECT id FROM application WHERE name = 'IHC-P'
- IHC-P [2,621] SELECT id FROM application WHERE name = 'IHC-Pfa'
- IHC-Pfa [1] SELECT id FROM application WHERE name = 'IP'
- IP [640] SELECT id FROM application WHERE name = 'RIA'
- RIA [2] SELECT id FROM application WHERE name = 'WB'
- WB [6,018] SELECT id FROM application WHERE name = 'pELISA'
- pELISA [99]
8,225 PRODUCTS
-
Catalogue Number: ABO12789-ABG
Category: antibody
Type: Polyclonal Primary Antibody - Unconjugated
Manufacturer Name: Abcepta
Description:
Application: ELISA FC ICC IF IHC-P WB IHC-Fr IHC
Unit(s): 100 ug
Datasheet ✔
-
Catalogue Number: AF4326A-ABG
Category: antibody
Type: Polyclonal Primary Antibody - Unconjugated
Manufacturer Name: Abcepta
Application: ELISA FC IF
Unit(s): 100 ug
Datasheet ✔
-
Catalogue Number: AF4329A-ABG
Category: antibody
Type: Polyclonal Primary Antibody - Unconjugated
Manufacturer Name: Abcepta
Application: ELISA FC IF
Unit(s): 100 ug
Datasheet ✔
-
Catalogue Number: AF4330A-ABG
Category: antibody
Type: Polyclonal Primary Antibody - Unconjugated
Manufacturer Name: Abcepta
Application: ELISA FC IF IHC
Unit(s): 100 ug
Datasheet ✔
-
Catalogue Number: AF4331A-ABG
Category: antibody
Type: Polyclonal Primary Antibody - Unconjugated
Manufacturer Name: Abcepta
Application: FC IF WB pELISA
Unit(s): 100 ug
Datasheet ✔
-
Catalogue Number: AM8688B-ABG
Category: antibody
Type: Monoclonal Primary Antibody - Unconjugated
Manufacturer Name: Abcepta
Description:
Application: FC WB
Unit(s): 200 ul, 50 ul
Datasheet ✔
-
Catalogue Number: AM8697B-ABG
Category: antibody
Type: Monoclonal Primary Antibody - Unconjugated
Manufacturer Name: Abcepta
Description:
Application: FC WB
Unit(s): 200 ul, 50 ul
Datasheet ✔
-
Catalogue Number: AM8701B-ABG
Category: antibody
Type: Monoclonal Primary Antibody - Unconjugated
Manufacturer Name: Abcepta
Description:
Application: FC
Unit(s): 200 ul, 50 ul
Datasheet ✔
-
Catalogue Number: AM8706B-ABG
Category: antibody
Type: Monoclonal Primary Antibody - Unconjugated
Manufacturer Name: Abcepta
Description:
Application: FC IHC-P WB
Unit(s): 200 ul, 50 ul
Datasheet ✔
-
Catalogue Number: AP10323B-ABG
Category: antibody
Type: Polyclonal Primary Antibody - Unconjugated
Manufacturer Name: Abcepta
Application: FC WB
Unit(s): 400 ul, 80 ul
Datasheet ✔